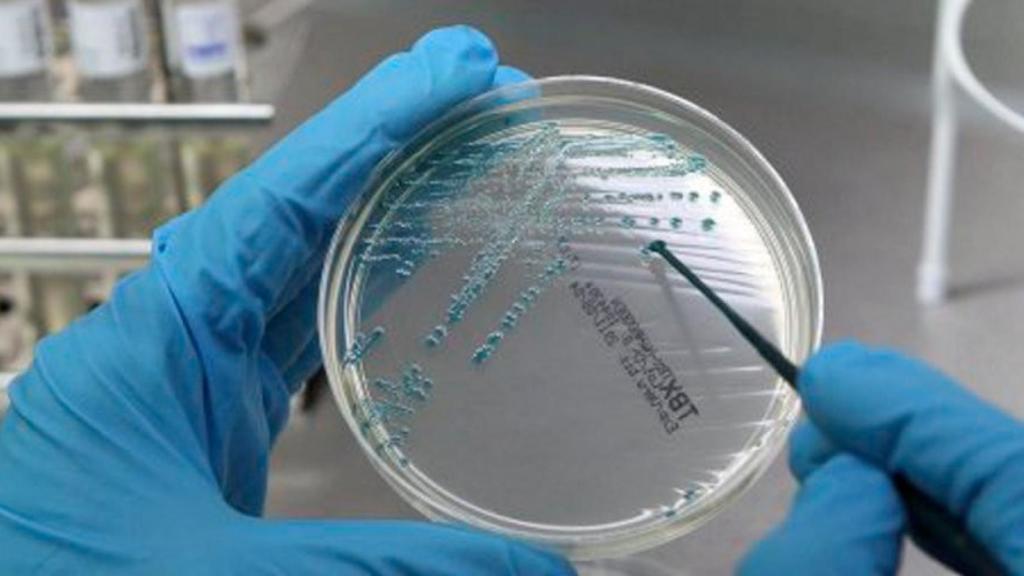
Investigación oncológica / EFE- Bernd Wuestneck

Investigación oncológica / EFE- Bernd Wuestneck
Expertos en la lucha contra el cáncer se dan cita en Barcelona
La capital catalana reúne a los máximos investigadores oncológicos para abordar los tratamientos contra la enfermedad
Noticias relacionadas
Los máximos expertos en investigación oncológica de todo el mundo tienen una cita en Barcelona. La próxima semana, los máximos exponentes en la lucha contra el cáncer acudirán a la capital catalana para abordar los protocolos de diagnóstico, los tratamientos, el seguimiento y el futuro de esta enfermedad.
El encuentro, que se celebrará los días 6 y 7 de marzo en el Paraninfo de la Facultad de Medicina de la Universidad de Barcelona, ha sido organizada por la Fundación Josep Carreras y el Instituto Catalán de Investigación y Estudios Avanzados (ICREA). Bajo el título: "Heterogeneidad tumoral y evolución del cáncer: desde la bioinformática hasta la práctica clínica", los expertos abordarán las futuras estrategias para luchar contra el cáncer.
Según los organizadores, los avances que en biología molecular y genómica de los últimos diez años han hecho que se inicie una nueva etapa en la investigación traslacional del cáncer. Hasta ahora, esta se centraba en el estudio del tumor como un conjunto homogéneo de células malignas. Pero el estudio ha dado un vuelco y en estos momentos se considera el tumor como un conjunto de subclones diferentes, tal y como explican los oncólogos de la Fundación Carreras.
Esto quiere decir que todos los tumores son ecosistemas de clones celulares que evolucionan. Una conclusión fundamental para el historial clínico de los pacientes, ya sea por el diagnóstico como por el tratamiento y seguimiento de la enfermedad, según los expertos.
LOS EXPERTOS
Todas estas apreciaciones son las que se analizarán en Barcelona la próxima semana. A la conferencia asistirán científicos como Josep Tabernero y Joan Seoane, del Instituto de Oncología del Hospital Vall d'Hebron (VHIO); Núria López-Bigas, del Instituto de Investigación Biomédica de Barcelona (IRB); Jaume Mora, jefe de oncología pediátrica del Hospital Sant Joan de Déu; y David Torrents, del Barcelona Supercomputing Center.
Asimismo, Pablo Menéndez, director científico del Campus Clínico-UB del Instituto de Investigación contra la Leucemia Josep Carreras; e Ignacio Varela, investigador del Instituto de Biotecnología y Bioingeniería de la Universidad de Cantabria, se darán cita en el encuentro de expertos internacionales.
Por su parte, desde el extranjero acudirán expertos como Carlo Maley, de la School of Life Science de la Arizona State University; John Dick, del Princess Margaret Center de Toronto; Peter Dirks, del Sick Children Hospital de Toronto; Christina Curtis de la Stanford University School of Medicine; Eric Hollander, del Fred Hutchinson Cancer Center de Seattle y Alberto Bardelli, Presidente de la Asociación Europea de Investigación Oncológica.
LA ENFERMEDAD EN CIFRAS
Hace unas semanas conociamos la incidencia del cáncer a nivel estatal, la cual ha crecido un 15% en apenas tres años, concretamente de 2012 a 2015, según la red de registros de ámbito nacional Redecan. En España, esta enfermedad causa una de cada cuatro muertes anuales. El número de nuevos casos crece continuamente y ya superan las previsiones en España para el año 2020. La principal causa es el envejecimiento de la población junto con otros factores de riesgo como es el tabaco, el alcohol, la obesidad, la contaminación o el sedentarismo.
Según datos de la Sociedad Española de Oncología Médica (SEOM), en 2015 se diagnosticaron 247.771 nuevos pacientes (148.827 varones y 98.944 mujeres), 1.000 casos más de lo que se preveía para 2020. Los tipos más frecuentes fueron colorrectal (41.441 nuevos casos), próstata (33.370), pulmón (28.347), mama (27.747) y vejiga (21.093).
El dato optimista recae en la prevención, ya que entre el 30 y el 40 % de las muertes por cáncer se podrían evitar con hábitos de vida saludables.